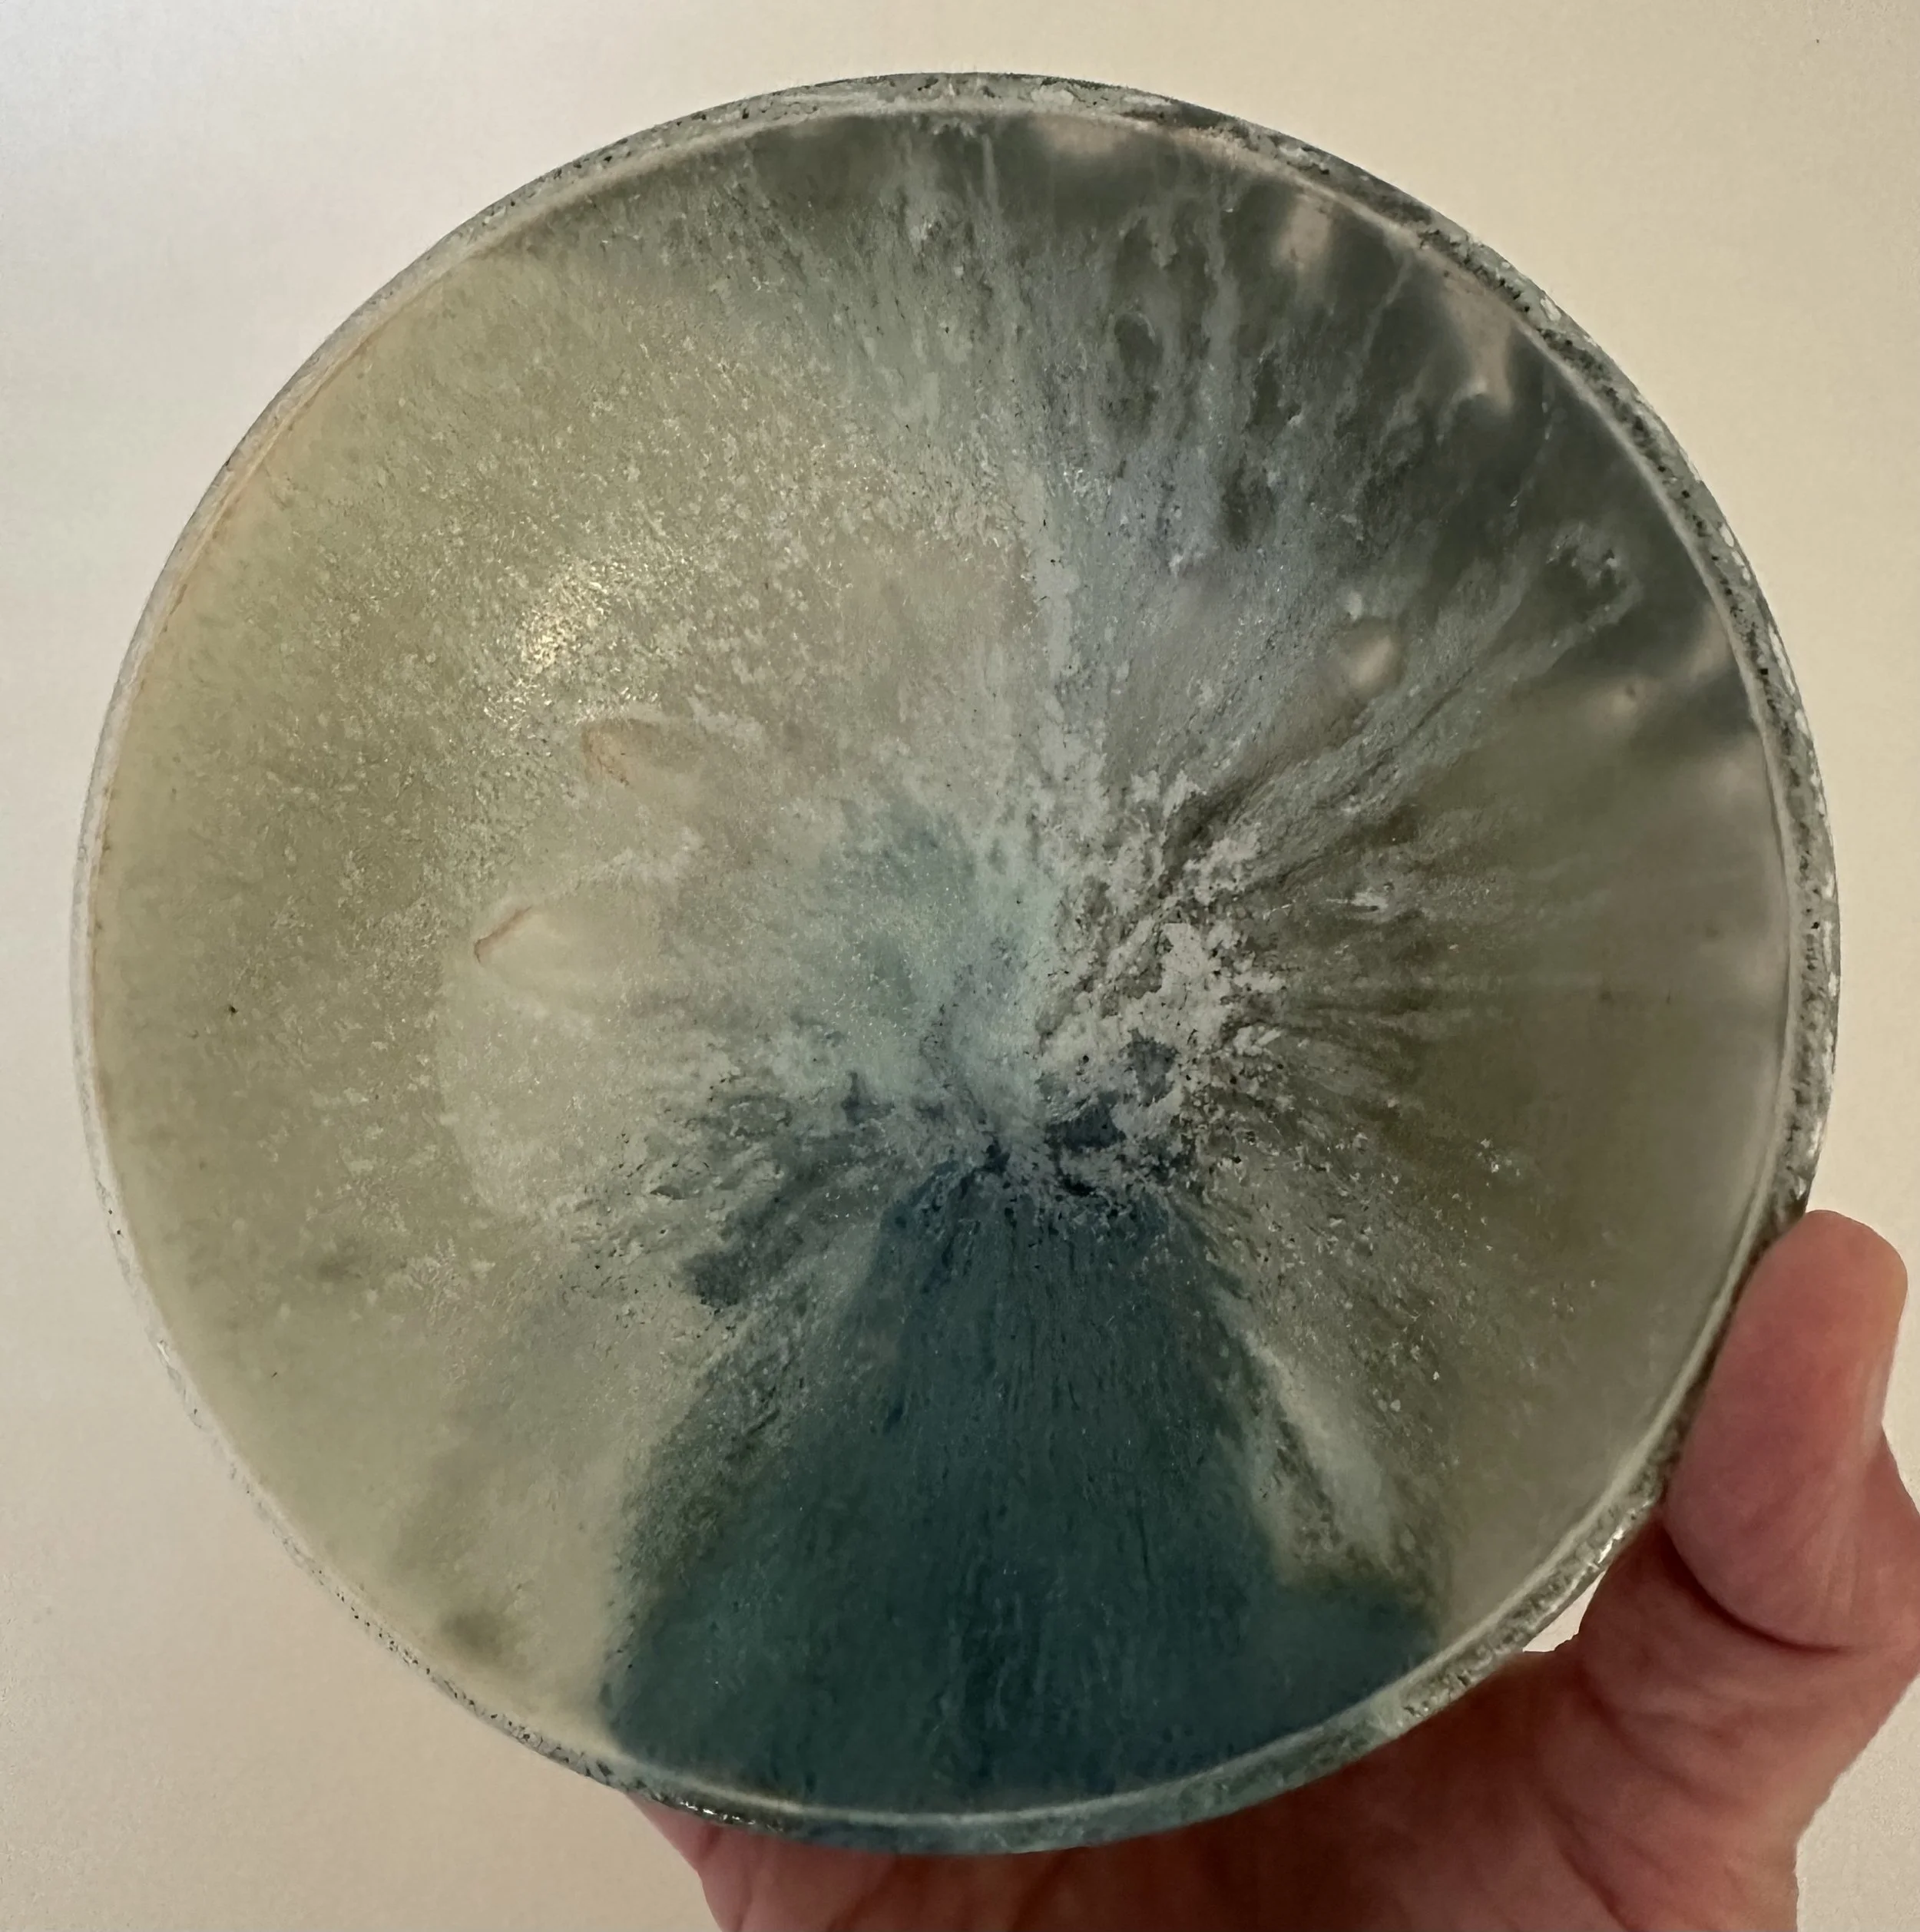
IMG_5570.jpeg

Wishing on Stars Bowl
sold out
Wishing on Stars Bowl
$18.00
Wheel-thrown, one-of-a-kind English porcelain bowl finished with an original glaze.
Approximately 6 Inches wide x 2.5 inches tall
A wonderful bowl for soup, salad, or anything your heart desires.
Microwave safe
Dishwasher-friendly, though hand washing with care is best
• Handmade Quality: Each distinctive mark and natural imperfection make the piece beautifully unique. •